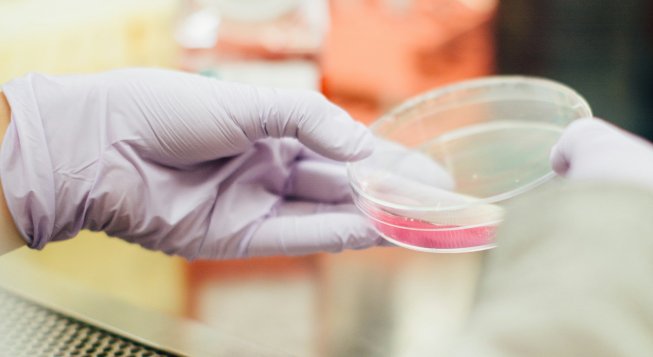
Scienza © Drew / Unsplash

Wired Health 2026: talk e dibattiti su salute, medicina e nuove tecnologie
Scienza © Drew / Unsplash
Scienza © Drew / Unsplash
Mercoledì 18 marzo 2026 Base Milano (via Bergognone 34, Milano) ospita la nona edizione di Wired Health, nona edizione dell’appuntamento gratuito e aperto al pubblico che offre una giornata di networking e aggiornamento, con incontri, dialoghi e approfondimenti, per comprendere come le innovazioni stiano trasformando medicina, salute e sistemi sanitari.
Realizzata con la partnership scientifica dell’Università Vita-Salute San Raffaele, l’edizione 2026 ha come parola chiave Beyond: un invito ad andare oltre i confini attuali della scienza medica, oltre le rigidità organizzative che frammentano la cura e oltre gli ostacoli che frenano l’espressione del talento umano. Il cuore dell’edizione 2026 sarà un racconto corale dell’evoluzione dell’healthcare, che intreccia ricerca scientifica, trasformazione organizzativa e valorizzazione del capitale umano.
Le porte di Base Milano si aprono alle 8.00 con un welcoming breakfast per dare il benvenuto ai partecipanti prima dell'inizio dei lavori. L’evento si svolge poi dalle 9.00 alle 18.30 includendo tre programmi in parallelo: keynote e panel plenari con oltre 40 speaker italiani e internazionali nella Sala Golgi; workshop tecnici e approfondimenti strategici sulle frontiere della sanità digitale nella Sala Helix; c'è poi l'Area Exhibit e Networking con startup e scaleup, accompagnata da spazi co-working per networking professionale.
Tanti gli ospiti nazionali e internazionali che saliranno sul palco: Reinhard Jahn, professore emerito e group leader al Max Planck Institute for Multidisciplinary Sciences di Göttingen, Premio Balzan per la Neurobiologia Molecolare; Aldo Faisal, professor of Ai & Neuroscience all’Imperial College di Londra e Chair in Digital Health all’Universität Bayreuth; Hannah Teichmann, neuroscienziata, co-fondatrice di Medical Microinstruments e advisor globale nel medtech, tra le voci più autorevoli all'incrocio tra robotica chirurgica e innovazione clinica; la founder e ceo di Clue Ida Tin, ideatrice del termine femtech; Davide Zaccagnini, co-founder e ceo di Agora Labs; il cto di Scarlet Jamie Cox.
Ancora, Anna Flavia d'Amelio Einaudi, consigliera delegata dell’Università Vita-Salute San Raffaele e diriettrice della Ricerca all'Irccs Ospedale San Raffaele; Gianvito Martino, prorettore alla Ricerca e alla Terza Missione UniSR, direttore scientifico dell'Irccs Ospedale San Raffaele; Pierpaolo Sileri, prorettore alla Didattica dell'Università Vita-Salute San Raffaele e direttore dell'Unità di Chirurgia Colorettale dell'Irccs Ospedale San Raffaele; il data protection officer dell’Istituto Superiore di Sanità Carlo Villanacci; il direttore del Lab of Cell Therapies all’Ospedale Gaslini di Genova Roberto Gramignoli; il responsabile dell’unità di ricerca Soft Robotics for Human Cooperation and Rehabilitation dell’Istituto Italiano di Tecnologia Antonio Bicchi; Elena Sini, chair del Board of Directors dell’Himss e cio di Gvm Care & Research; Antonio Passaro, direttore f.f. Divisione di Oncologia Toracica dell’Istituto Europeo di Oncologia Irccs; Marco Demaria, orofessore di Invecchiamento Cellulare presso la University of Groningen e group leader del laboratorio Cellular Senescence and Age-related Pathologies presso lo European Research Institute for the Biology of Ageing.
Sul sito ufficiale di Wired Health, il programma dettagliato e aggiornato degli eventi e le modalità di iscrizione.